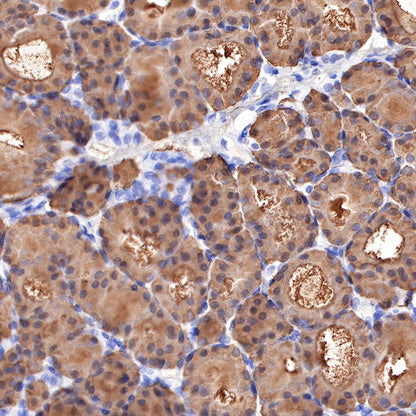

Product Details
Product Details
Product Specification
Host | Rabbit |
Antigen | Thyroglobulin |
Synonyms | Tg, TG |
Immunogen | Native protein |
Location | Secreted |
Accession | P01266 |
Clone Number | SDT-209-297 |
Antibody Type | Rabbit mAb |
Application | IHC-P, IF |
Reactivity | Hu, Ms, Rt |
Purification | Protein A |
Concentration | 0.125 mg/ml |
Physical Appearance | Liquid |
Storage Buffer | PBS, 40% Glycerol, 0.05% BSA, 0.03% Proclin 300 |
Stability & Storage | 12 months from date of receipt / reconstitution, -20 °C as supplied |
Dilution
application | dilution | species |
IHC-P | 1:1000 | null |
IF | 1:125 | null |
Background
Thyroglobulin is a large protein used by the thyroid gland to make thyroid hormones (T4 and T3) and store iodine in the body, made in the thyroid by the so-called follicular cells. When the thyroid is stimulated by thyroid-stimulating hormone (TSH), it combines iodine with thyroglobulin to create the hormones T4 and T3. While most thyroglobulin stays in the thyroid, a small amount leaks out into the bloodstream. Levels in the blood are directly proportional to the size of the thyroid. For example, thyroid cancer cells enlarge the gland and make thyroglobulin in high amounts. Any disorder that increases the size of the thyroid (cancer, autoimmune disease, nodules, etc.) can raise thyroglobulin levels.
Picture
Picture
Immunohistochemistry



IHC shows positive staining in paraffin-embedded mouse thyroid. Anti-Thyroglobulin antibody was used at 1/1000 dilution, followed by a HRP Polymer for Mouse & Rabbit IgG (ready to use). Counterstained with hematoxylin. Heat mediated antigen retrieval with Tris/EDTA buffer pH9.0 was performed before commencing with IHC staining protocol.



Immunofluorescence

Negative control:IF shows negative staining in paraffin-embedded human cardiac muscle. Anti-Thyroglobulin antibody was used at 1/125 dilution and incubated overnight at 4°C. Goat polyclonal Antibody to Rabbit IgG - H&L (Alexa Fluor® 488) was used as secondary antibody at 1/1000 dilution. Counterstained with DAPI (Blue). Heat mediated antigen retrieval with Tris/EDTA buffer pH9.0 was performed before commencing with IF staining protocol.